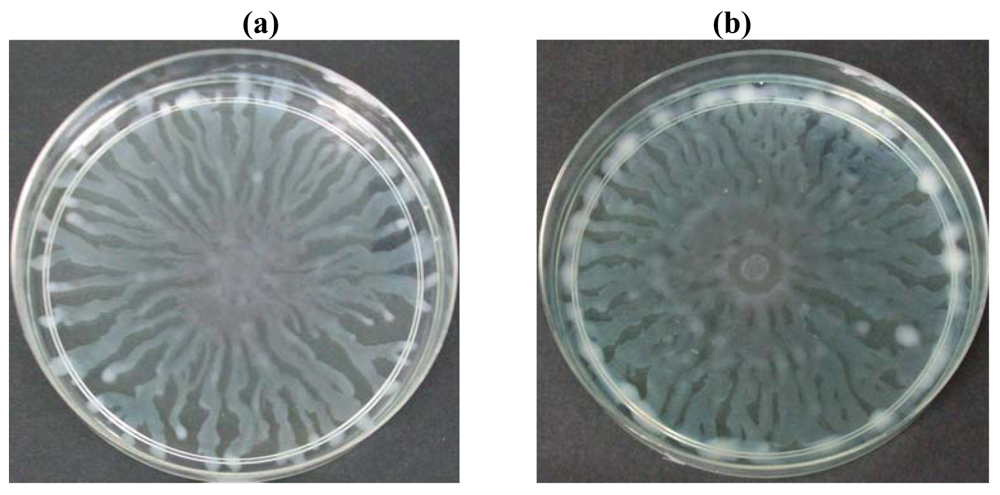
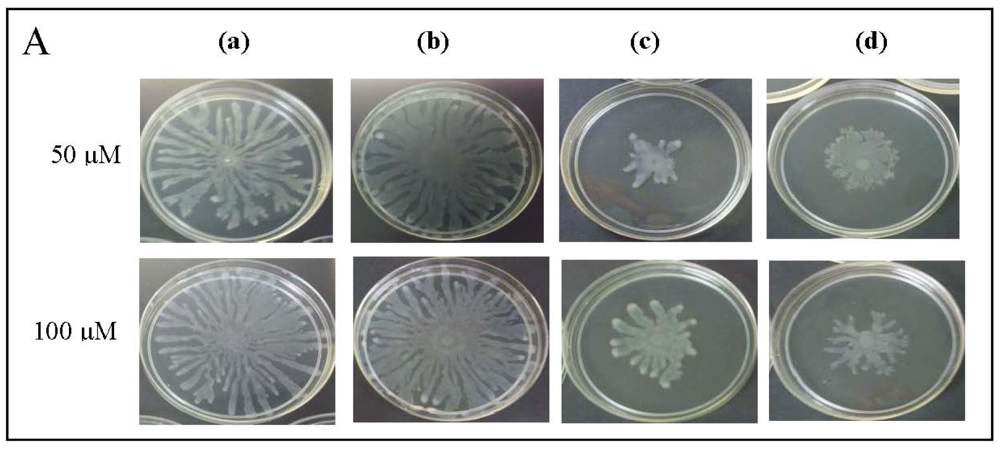

Abstract
Quorum sensing controls the virulence determinants in most proteobacteria. In this work, the hexane, chloroform and methanol extracts of an Ayurveda spice, namely clove (Syzygium aromaticum), shown anti-quorum sensing activity. Hexane and methanol extracts of clove inhibited the response of C. violaceum CV026 to exogenously supplied N‐hexanoylhomoserine lactone, in turn preventing violacein production. Chloroform and methanol extracts of clove significantly reduced bioluminescence production by E. coli [pSB1075] grown in the presence of N-(3-oxododecanoyl)-l-homoserine lactone. We demonstrated that clove extract inhibited quorum sensing-regulated phenotypes in Pseudomonas aeruginosa PA01, including expression of lecA::lux (by hexane extract), swarming (maximum inhibition by methanol extract), pyocyanin (maximum inhibition by hexane extract). This study shows that the presence of natural compounds that exhibit anti-quorum sensing activity in the clove extracts may be useful as the lead of anti-infective drugs.1. Introduction
Bacteria communicate with each other within their vicinity using chemical signalling molecules which are known as autoinducers. Quorum sensing (QS) relies on these autoinducers to control gene expression in response to changes in bacterial cell density [1]. Several signalling molecules have been identified and the most common type in most Gram-negative bacteria are the N-acylhomoserine lactones (AHLs) [2]. Most recently, AHL production has been shown in an oral bacterium, namely Klebsiella pneumoniae [3]. At a certain threshold, where AHL concentration increases due to increased bacterial cell density, AHL will bind to its cognate receptor (luxR protein) and transcription regulation of the target genes will take place [4].
QS regulates diverse bacterial functions including antibiotic formation, virulence factor expression, luminescence, biofilm formation, motility and pigment production [5,6]. For example, Pseudomonas aeruginosa PAO1 is an important opportunistic pathogen, primarily infecting immunocompromised patients [7]. It uses QS to regulate several extracellular virulence factors such as LasA protease, LasB elastase, pyoverdin, pyocyanin and biofilm [8]. There are two QS systems in P. aeruginosa PAO1, firstly the AHL-based LasI/RhlI (which synthesize N-(3-oxododecanoyl)-l-homoserine lactone (3-oxo-C12-HSL) and N-butanoylhomoserine lactone (C4-HSL), respectively) and its regulator LasR/RhlR. Secondly, there is another QS system which employs 2-heptyl-3-hydroxy-4-quinolone (PQS) as their signal molecule for virulence factor production [9,10].
Thus, inhibiting QS, or anti-QS is an important anti-infective measure that does not rely on antibiotics [11]. Anti-QS agents will inhibit the QS mechanism and attenuate the virulence determinants and are unlikely to cause drug-resistance problems [12]. Recently, studies have found that many eukaryotes produce anti-QS compounds [13]. For example, the marine alga Delisea pulchra produces halogenated furanone compounds which are analogs to naturally occurring AHL signal molecules and appear to act against AHLs signal receptor proteins [14].
Originating in India, Ayurveda is known as the oldest of all traditional systems of medicine. In fact, the ancient text of Ayurveda reports more than 2,000 plant species for their therapeutic potentials [15]. Herbs and spices are common ingredients used in food preparation among the Indians because of their flavouring and preservative properties [16]. In Ayurveda, large number of herbs and spices are used as preventive and curative medicines. Screening of herbal medicinal plants for their bio-activity is important since traditional medicines are used as complementary and alternative medicine widely.
Syzygium aromaticum (cloves), a spice used in Ayurveda, is a source of anti-microbial agents against oral bacteria that are commonly associated with dental caries and periodontal disease [17]. It was also reported that S. aromaticum have been successfully used for asthma and various allergic disorders by oral administration [18]. Previous studies have shown that clove oil possesses anti-QS activities towards C. violaceum CV026 and swarming motility in P. aeruginosa PA01 [19]. Therefore, the present work studied the potential of the hexane, chloroform and methanol extract of cloves, dried flower buds of Syzygium aromaticum (L.) Merr. et Perry as QS inhibitor.
2. Experimental Section
2.1. Extraction
Dried clove buds were obtained from local store in Kuala Lumpur, Malaysia, in 2010. The clove buds were further dried and blended into a fine dry powder. The clove powder (50 g) was soaked separately with 250 mL of hexane, chloroform and methanol in a 500 mL conical flask for 48 hours at room temperature, without shaking. The respective solvents were filtered through Whatman filter paper No. 1 and concentrated on a rotary vacuum evaporator. Concentrated extracts were then dried in a laminar hood and were further dried in a desiccator to obtain the crude extract. The crude extract was reconstituted in dimethyl sulfoxide (DMSO) to make a stock solution of 10 mg/mL and stored at −20 °C. Further dilutions were made with ultrapure water before use. The extract was also checked for sterility by streaking on LB agar.
2.2. Bacterial Strains, Plasmids and Growth Conditions
Bacterial strains and plasmids used in this study are listed in Table 1. All the strains were cultured in Luria Bertani (LB) broth (1% peptone, 0.5% yeast extract, 0.5% NaCl, per 100 mL distilled water) with shaking (220 rpm). Chromobacterium violaceum CV026 was grown at 28 °C while all other strains were routinely cultured at 37 °C supplemented with antibiotic when necessary.
2.3. Anti-QS Against C. Violaceum CV026
Fifteen milliliters of warm molten LB agar were seeded overnight with C. violaceum CV026 culture (3 mL) grown to an OD600 of approximately 1.2 and N-hexanoylhomoserine lactone (C6-HSL, 0.15 μg/mL) as an exogenous AHL. The agar were gently mixed and poured immediately into a Petri dish. Wells (diameter of 4 mm) were made on the solidified agar plate. Sterile plant extract was loaded into the well (40 μL per well). (+)-Catechin [24] was used as positive control for QS inhibition while DMSO as negative control. The plate was incubated for 18–24 hours at 28 °C to check for the violacein inhibition. Halo zone showed anti-QS while clear and transparent zones indicated antimicrobial activity. For all instances, viability of biosensor cells was determined to rule out possibility of antibiotic effects against the biosensors.
2.4. Bioluminescence Assays
Bioluminescence and optical density were determined in 96-well microtitre plates using a Tecan luminometer (InfiniteM200) as previously described with slight modification [25]. Briefly, overnight cultures of E. coli [pSB401], E. coli [pSB1075] or P. aeruginosa PAO1 lecA::lux were diluted 1:100 in sterile, fresh LB medium, and aliquot (180 μL) with appropriate exogenous AHLs were loaded into each well containing 20 μL of sterile plant extract. For E. coli [pSB401] and E. coli [pSB1075], N-(3-oxohexanoyl)-l-homoserine lactone (3-oxo-C6-HSL, 0.005 μg/mL) and 3-oxo-C12-HSL (0.1 μg/mL) were supplemented, respectively. Bioluminescence and optical density were automatically simultaneously determined every 30 min for 24 hours. Bioluminescence is given as relative light units (RLU) per unit of optical density at 495 nm, which accounted for the influence of increased growth on the total bioluminescence. Experiments were done in triplicate and repeated three times.
2.5. Inhibition of QS-Mediated Virulence Determinants
2.5.1. Swarming Assay
The swarm plates of P. aeruginosa PAO1 were prepared using 0.5% Bacto agar, 0.5% peptone, 0.2% yeast extract and 1.0% glucose, per 100 ml distilled water [26]. A 250 μL of sterile clove extract was seeded with 5 mL of the agar and poured immediately on a 10 mL of pre-warmed agar plate as an overlay. Two microliters of the P. aeruginosa PAO1 culture was inoculated at the center of the agar surface and the plate was incubated for 16 hours at 37 °C. To determine whether exogenous supplied AHLs could restore P. aeruginosa PAO1 swarming motility, warm swarm agar was added with C4-HSL), 3-oxo-C12-HSL or both. AHLs were applied at the concentrations of 50 μM and 100 μM.
2.5.2 Pyocyanin Assay
Pyocyanin was extracted from overnight P. aeruginosa PAO1 culture supernatant as previously described [27] with slight modifications. Briefly, 250 μL of plant extracts were mixed with freshly prepared P. aeruginosa PAO1 culture (5 mL, OD600 = 0.1) and incubated overnight at 37 °C. Chloroform (3 mL) was added to the P. aeruginosa PAO1 culture supernatant and mixed vigorously. The chloroform layer was mixed with 1 mL of HCl (0.2 M). After centrifugation (10 min, 28 °C, 8,000 rpm), the OD of the HCl layer was measured at 520 nm against 0.2 M HCl using an UV/Vis spectrophotometer UV-1601 (Shimadzu, Tokyo, Japan).
2.6. Statistical Analysis
All the results represent the average of three independent experiments. The data were presented as mean ± standard deviation (SD) and analysed by one-way analysis of variance with P < 0.05 being significant, calculated using the GraphPad Prism 5 statistical software.
3. Results and Discussion
3.1. Clove Crude Extracts Showed Anti-QS Properties
Initial screening of clove extracts for anti-QS activities were done using the C. violaceum CV026 as preliminary bioassay. C. violaceum CV026 is unable to produce the purple pigment violacein unless C6-HSL or a variety of other short-chain AHLs were supplied exogenously [20]. Increased amount of clove methanolic extract showed stronger inhibition of C. violaceum CV026 responding to AHL, thus inhibited its violacein production. However, hexane extract only showed observable inhibition at higher concentration of 3 mg/mL (Figure 1). Therefore, clove methanolic extract had a stronger inhibition activity than hexane extract although both extracts shown to inhibit C. violaceum CV026. Chloroform extract shows no activity against C. violaceum CV026. Different solvents, hexane (more non polar), chloroform (non polar) and methanol (polar) were used in the plant extractions because of their ability to extract various compounds due to different polarity. Consequently, different degree of anti-QS activities was observed by these extracts. As a prerequisite, we have verified that the extracts did not show bactericidal effect on all biosensor cells as determined by viability of cells (data not shown). In the present experimental condition, DMSO (at 1, 2 and 3 mg/mL) did not show significant antimicrobial effect in the performed assays when applied at these concentrations.
3.2. Bioluminescence Assays
3.2.1. Inhibition of Luminescence Produced by E. coli [pSB401] and E. coli [pSB1075]
The hexane, chloroform and methanol extracts of clove were assayed using lux-based biosensor strains E. coli [pSB401] and E. coli [pSB1075] in 96-microtitre well plates. E. coli [pSB401] and E. coli [pSB1075] biosensor strains respond by the emission of light, preferentially to the presence of exogenous AHLs with acyl chains from six to eight carbons in length (such as 3-oxo-C6-HSL, C6-HSL and N-octanoylhomoserine lactone (C8-HSL)) or AHLs with acyl chains of 10–14 carbons in length, respectively [23].
In this study, increasing concentration of hexane extract of clove showed significant inhibition of bioluminescence produced by E. coli [pSB401] biosensor strain in the presence of 3-oxo-C6-HSL compared to DMSO which served as control (Figure 2). Other extracts only showed observable bioluminescence inhibition. On the other hand, increasing concentration of chloroform and methanol significantly inhibit bioluminescence production by E. coli [pSB1075] strains grown in the presence of 3-oxo-C12-HSL (Figure 3). Hexane extracts of clove only showed significant inhibition at 3 mg/mL concentration compared to DMSO which served as control.


3.2.2. Inhibition of P. aeruginosa PAO1 lecA::lux Activity
Hexane extract of clove showed significant inhibition of the P. aeruginosa PAO1 lecA expression as judged by the reduced bioluminescence of P. aeruginosa PAO1 lecA::lux fusion. However, other clove extracts only slightly inhibited the expression of the P. aeruginosa PA01 lecA::lux reporter fusion (Figure 4). This result suggests that P. aeruginosa PAO1 LecA virulence factor could be interrupted by the clove crude extract without affecting its growth. In these assays, all the data were analyzed using ANOVA and Dunnet's post test to compare the plant extracts (hexane, chloroform and methanol) as compared to the control (DMSO). Therefore, significant results shown are due to the effect of the plant extracts but not DMSO.
3.3. Inhibition of P. aeruginosa PAO1 Virulence Factors
To further explore anti-QS potential of clove extracts, further assays were done on inhibition of P. aeruginosa PAO1 swarming and pyocyanin production. The hexane, chloroform and methanol extracts of clove were assayed for inhibition of P. aeruginosa PA01 swarming motility. Maximum reduction of swarming was observed in the swarming plates containing clove methanolic extract followed by chloroform extract compared with control (DMSO) while hexane extract showed no observable reduction (Figure 5). We further verified whether P. aeruginosa PA01 swarming could be restored by the addition of exogenous AHLs (C4-HSL, 3-oxo-C12-HSL, and both; applied at 50 μM and 100 μM). It is clearly shown that clove methanolic extract displays consistent swarming motility inhibition regardless of the types of AHLs supplemented to the swarm agars (Figure 6). C4-HSL and 3-oxo-C12-HSL were chosen because P. aeruginosa PA01 employs these AHLs as its natural QS molecules to control various QS-mediated phenotypes. We further demonstrated that even when both AHLs were added at a very high concentration (100 μM), swarming of P. aeruginosa PA01 was not restored significantly (Figure 6). Addition of high concentration of AHLs failed to restore swarming of P. aeruginosa PA01 leads to the speculation that clove extracts may contain active molecules that show anti-QS activity that may not compete with AHLs to bind the cognate receptor at the same active site. This, however, requires further work on studying the interaction of clove extracts and P. aeruginosa PA01 luxI and luxR homologues.

QS-regulated swarming motility has been characterized as form of flagella-dependent movement on a viscous environments such as semi-solid agar surfaces while pyocyanin is characterized as a blue pigment and redox-active phenazine compound that generate reactive oxygen intermediates [28,29]. Hexane and methanolic but not chloroform extracts of clove showed reduction in pyocyanin formation (Figure 7). Both swarming and pyocyanin are produced and regulated by the rhl system in P. aeruginosa [30,31]. Therefore, collectively inhibition of P. aeruginosa PAO1 swarming motility and pyocyanin production suggests the presence of rhl inhibitor in the clove extracts.
Various extracts of clove inhibited E. coli [pSB401] (carries the luxR receptor gene) and E. coli [pSB1075] (carries the lasR receptor gene) [23] indicating the crude extracts of clove contain compounds that could serve as lead anti-QS compounds. Inhibition of PA01 lecA::lux fusion suggests that clove extracts might interfere with the QS-regulated lux, rhl and las systems. Clove is a traditional Ayurvedic medicinal plant, it is also widely used as spice in cuisine worldwide, and it has not been shown to exhibit adverse effects. Hence, it should be regarded as safe. However, for future work on clinical trials or application, toxicity and potential adverse effects must first be ruled out. It is suggested that cytotoxicity test should be carried out to ascertain the safety of the compounds. Taken these results together, clove extracts are shown to possess active compounds that can significantly inhibit various virulence determinants in human pathogen P. aeruginosa PAO1.
4. Conclusions/Outlook
Continuous emergence of multidrug-resistant bacteria caused increased need of anti-pathogenic and anti-infective strategy to combat bacterial infections. Natural products provide alternative medicine for treating emerging bacterial infections without leading to antibiotic resistance. Previous studies have shown anti-QS activity in plants [10,11,18,32,33]. The presence of active compounds exhibiting anti-QS activity in the clove extracts maybe useful for the development of anti-infective drugs. Our laboratory is currently elucidating the chemical structure of these active compounds to understand the anti-QS mechanism in QS bacteria.
Acknowledgments
Kok-Gan Chan thanks the University of Malaya for High Impact Research Grant (UM-MOHE HIR Grant Number A-000001-50001) for financial support.
References
- Schauder, S.; Bassler, B.L. The languages of bacteria. Genes Dev. 2001, 15, 1468–1480. [Google Scholar]
- Eberhard, A.; Burlingame, A.L.; Eberhard, C.; Kenyon, G.L.; Nealson, K.H.; Oppenheimer, N.J. Structural identification of autoinducer of Photobacterium fischeri luciferase. Biochemistry 1981, 163, 2444–2449. [Google Scholar]
- Yin, W.F.; Purmal, K.; Chin, S.; Chan, X.Y.; Koh, C.L.; Sam, C.K.; Chan, K.G. N-acyl homoserine lactone production by Klebsiella pneumoniae isolated from human tongue surface. Sensors 2012, 12, 3472–3483. [Google Scholar]
- Fuqua, W.C.; Winans, S.C.; Greenberg, E.P. Quorum sensing in bacteria: the LuxR LuxI family of cell density responsive transcriptional regulators. J. Bacteriol. 1994, 176, 269–275. [Google Scholar]
- Fuqua, C.; Greenberg, E.P. Listening in on bacteria: acyl-homoserine lactone signalling. Nat. Rev. Mol. Cell Biol. 2002, 3, 685–695. [Google Scholar]
- Whitehead, N.A.; Barnard, A.M.; Slater, H.; Simpson, N.J.; Salmond, G.P. Quorum sensing in Gram-negative bacteria. FEMS Microbiol. Rev. 2001, 25, 365–404. [Google Scholar]
- Govan, J.R.; Deretic, V. Microbiol pathogenesis in cystic fibrosis: Mucoid Pseudomonas aeruginosa and Burkholderia cepacia. Microbiol. Rev. 1996, 60, 539–574. [Google Scholar]
- Lyczak, J.B.; Cannon, C.L.; Pier, G.B. Lung infections associated with cystic fibrosis. Clin. Microbiol. Rev. 2002, 15, 194–222. [Google Scholar]
- Gómez, P.J.; Pozuelo de Felipe, M.J.; Pinell, F.L.; Garcia de los Rios, J.E. Quorum-sensing in Pseudomonas aeruginosa and Salmonella: Active natural compounds as antagonists. In Communicating Current Research and Educational Topics and Trends in Applied Microbiology; Méndez-Vilas, A., Ed.; Formatex Research Center: Spain, 2007; Volume 1, pp. 41–51. [Google Scholar]
- Pesci, E.C.; Pearson, J.P.; Seed, P.C.; Iglewski, B.H. Regulation of las and rhl quorum sensing in Pseudomonas aeruginosa. J. Bacteriol. 1997, 179, 3127–3132. [Google Scholar]
- Vattem, D.A.; Mihalik, K.; Crixell, S.H.; McLean, R.J.C. Dietary phytochemicals as quorum sensing inhibitors. Fitoterapia 2007, 78, 302–310. [Google Scholar]
- Adonizio, A.; Kong, K.F.; Mathee, K. Inhibition of quorum sensing-controlled virulence factor production in Pseudomonas aeruginosa by South Florida plant extracts. Antimicrob. Agents Ch. 2008, 52, 198–203. [Google Scholar]
- Gonzalez, J.E.; Keshavan, N.D. Messing with bacterial quorum sensing. Microbiol. Mol. Biol Rev. 2006, 70, 859–875. [Google Scholar]
- Manefield, M.; de Nys, R.; Kumar, N.; Read, R.; Givskov, M.; Steinberg, P.; Kjelleberg, P. Evidence that halogenated furanones from Delisea pulchra inhibit acylated homoserine lactone (AHL)-mediated gene expression by displacing the AHL signal from its receptor protein. Microbiology 1999, 145, 283–291. [Google Scholar]
- Mukherjee, P.K.; Wahile, A. Integrated approaches towards drug development from Ayurveda and other Indian system of medicines. J. Ethnopharmacol. 2006, 103, 25–35. [Google Scholar]
- Darmadji, P.; Izumimoto, M.; Ketaoka, K. Antibacterial effect of spices on fermented meat. Agrosains 1993, 83, 1–6. [Google Scholar]
- Cai, L.; Wu, C.D. Compounds from Syzygium aromaticum possessing growth inhibitory activity against oral pathogens. J. Nat. Prod. 1996, 59, 987–990. [Google Scholar]
- Kim, H.M.; Lee, E.H.; Hong, S.H.; Song, H.J.; Shin, M.K.; Kim, S.H.; Shin, T.Y. Effect of Syzygium aromaticum extract on immediate hypersensitivity in rats. J. Ethnopharmacol. 1998, 60, 125–131. [Google Scholar]
- Khan, M.S.A.; Zahin, M.; Hasan, S.; Husain, F.M.; Ahmad, I. Inhibition of quorum sensing regulated bacterial functions by plant essential oils with special reference to clove oil. Lett. Appl. Microbiol. 2009, 49, 354–360. [Google Scholar]
- McClean, K.H.; Winson, M.K.; Fish, L.; Taylor, A.; Chhabra, S.R.; Camara, M.; Daykin, M.; Lamb, J.H.; Swift, S.; Bycroft, B.W.; Stewart, G.S.; Williams, P. Quorum sensing and Chromobacterium violaceum: Exploitation of violacein production and inhibition for the detection of N-acylhomoserine lactones. Microbiology 1997, 143, 3703–3711. [Google Scholar]
- Chan, K.G; Atkinson, S.; Mathee, K.; Sam, C.K.; Chhabra, S.R.; Camara, M.; Koh, C.L.; Williams, P. Characterization of N-acylhomoserine lactone degrading bacteria associated with the Zingiber officinale (ginger) rhizosphere: Co-existence of quorum quenching and quorum sensing in Acinetobacter and Burkholderia. BMC Microbiol. 2011, 11, 51–63. [Google Scholar]
- Winzer, K.; Falconer, C.; Garber, N.C.; Diggle, S.P.; Cámara, M.; Williams, P. The Pseudomonas aeruginosa lectins PA-IL and PA-IIL are controlled by quorum sensing and by RpoS. J. Bacteriol. 2000, 182, 6401–6411. [Google Scholar]
- Winson, M.K.; Swift, S.; Fish, L.; Throup, J.P.; Jorgensen, F.; Chhabra, S.R.; Bycroft, B.W.; Williams, P.; Stewart, G.S. Construction and analysis of luxCDABE-based plasmid sensors for investigating N-acyl homoserine lactone-mediated quorum sensing. FEMS Microbiol. Lett. 1998, 163, 185–192. [Google Scholar]
- Vandeputte, O.M.; Kiendrebeogo, M.; Rajaonson, S.; Diallo, B.; Mol, A.; El Jaziri, M.; Baucher, M. Identification of catechin as one of the flavonoids from Combretum albiflorum bark extract that reduces the production of quorum-sensing-controlled virulence factors in Pseudomonas aeruginosa PAO1. Appl. Environ. Microbiol. 2010, 76, 243–253. [Google Scholar]
- Sio, C.F.; Otten, L.G.; Cool, R.H.; Diggle, S.P.; Braun, P.G.; Bos, R.; Daykin, M.; Camara, M.; Williams, P.; Quax, W.J. Quorum quenching by an N-acyl-homoserine lactone acylase from Pseudomonas aeruginosa PAO1. Infect. Immun. 2006, 74, 1673–1682. [Google Scholar]
- Kinscherf, T.G.; Willis, D.K. Swarming by Pseudomonas syringae B728a requires gacS (lemA) and gacA but not the acyl-homoserine lactone biosynthetic gene ahlI. J. Bacteriol. 1999, 181, 4133–4136. [Google Scholar]
- Essar, D.W.; Eberly, L.; Hadero, A.; Crawford, I. Identification and characterization of genes for a second anthranilate synthase in Pseudomonas aeruginosa: Interchangeability of the two anthranilate synthases and evolutionary implications. J. Bacteriol. 1990, 172, 884–900. [Google Scholar]
- Harshey, R.M. Bacterial motility on a surface: Many ways to a common goal. Annu. Rev. Microbiol. 2003, 57, 249–273. [Google Scholar]
- Hassett, D.J.; Charniga, L.; Bean, K.; Ohman, D.E.; Cohen, M.S. Response of Pseudomonas aeruginosa to pyocyanin: Mechanisms of resistance, antioxidant defenses, and demonstration of a manganese-cofactored superoxide dismutase. Infect. Immun. 1992, 60, 328–336. [Google Scholar]
- De Kievit, T.R.; Iglewski, B.H. Bacterial quorum sensing in pathogenic relationships. Infect. Immun. 2000, 68, 4839–4849. [Google Scholar]
- Kohler, T.; Curty, L.K.; Barja, F.; van Delden, C.; Pechere, J.C. Swarming of Pseudomonas aeruginosa is dependent on cell-to-cell signaling and requires flagella and pili. J. Bacteriol. 2000, 182, 5990–5996. [Google Scholar]
- Teplitski, M.; Robinson, J.B.; Bauer, W.D. Plants secrete substances that mimic bacterial N-acyl homoserine lactone signal activities and affect population density-dependent behaviors in associated bacteria. Mol. Plant. Microbe. Interact. 2000, 13, 637–648. [Google Scholar]
- Koh, K.H.; Tham, F.Y. Screening of traditional Chinese medicinal plants for quorum-sensing inhibitors activity. J. Microbiol. Immunol. Infect. 2011, 44, 144–148. [Google Scholar]
© 2012 by the authors; licensee MDPI, Basel, Switzerland. This article is an open access article distributed under the terms and conditions of the Creative Commons Attribution license (http://creativecommons.org/licenses/by/3.0/).